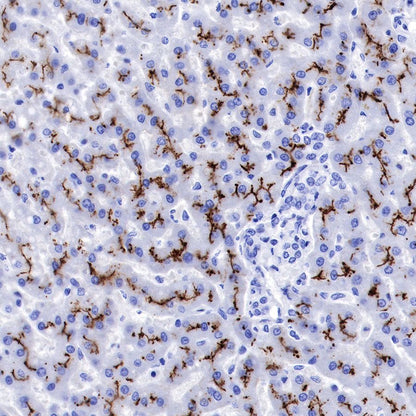

IHC shows positive staining in paraffin-embedded human liver. Anti-BSEP antibody was used at 1/1000 dilution, followed by a HRP Polymer for Mouse & Rabbit IgG (ready to use). Counterstained with hematoxylin. Heat mediated antigen retrieval with Tris/EDTA buffer pH9.0 was performed before commencing with IHC staining protocol.
Product Details
Product Details
Product Specification
| Host | Rabbit |
| Antigen | BSEP |
| Synonyms | Bile salt export pump, ATP-binding cassette sub-family B member 11, ABCB11 |
| Immunogen | Synthetic Peptide |
| Location | Cell membrane |
| Accession | O95342 |
| Clone Number | SDT-045-13 |
| Antibody Type | Rabbit mAb |
| Application | IHC-P, IF |
| Reactivity | Hu |
| Purification | Protein A |
| Concentration | 0.25 mg/ml |
| Physical Appearance | Liquid |
| Storage Buffer | PBS, 40% Glycerol, 0.05% BSA, 0.03% Proclin 300 |
| Stability & Storage | 12 months from date of receipt / reconstitution, -20 °C as supplied |
Dilution
| application | dilution | species |
| IHC-P | 1:1000 | |
| IF | 1:1000 |
Background
The bile salt export pump BSEP is critically involved in secretion of bile salts into bile. Its function can be disturbed or abolished by inherited mutations. This will lead to progressive intrahepatic cholestais and severe liver disease. In addition to mutations, Bsep can be inhibited by acquired factors such as for example xenobiotics or drugs, aberrant bile salt metabolites or pregnancy. This inhibition will lead to acquired cholestasis. Some drugs are now known to be competitive inhibitors of Bsep. In addition, a polymorphism in the gene coding for Bsep has been identified as a potential susceptibility factor for acquired cholestasis [PMID: 20028269].
Picture
Picture
Immunohistochemistry


IHC shows positive staining in paraffin-embedded human liver. Anti-BSEP antibody was used at 1/1000 dilution, followed by a HRP Polymer for Mouse & Rabbit IgG (ready to use). Counterstained with hematoxylin. Heat mediated antigen retrieval with Tris/EDTA buffer pH9.0 was performed before commencing with IHC staining protocol.

IHC shows positive staining in paraffin-embedded human hepatocellular carcinoma. Anti-BSEP antibody was used at 1/1000 dilution, followed by a HRP Polymer for Mouse & Rabbit IgG (ready to use). Counterstained with hematoxylin. Heat mediated antigen retrieval with Tris/EDTA buffer pH9.0 was performed before commencing with IHC staining protocol.

Negative control: IHC shows negative staining in paraffin-embedded human tonsil. Anti-BSEP antibody was used at 1/1000 dilution, followed by a HRP Polymer for Mouse & Rabbit IgG (ready to use). Counterstained with hematoxylin. Heat mediated antigen retrieval with Tris/EDTA buffer pH9.0 was performed before commencing with IHC staining protocol.

Negative control: IHC shows negative staining in paraffin-embedded human colon cancer. Anti-BSEP antibody was used at 1/1000 dilution, followed by a HRP Polymer for Mouse & Rabbit IgG (ready to use). Counterstained with hematoxylin. Heat mediated antigen retrieval with Tris/EDTA buffer pH9.0 was performed before commencing with IHC staining protocol.

Negative control: IHC shows negative staining in paraffin-embedded human breast cancer. Anti-BSEP antibody was used at 1/1000 dilution, followed by a HRP Polymer for Mouse & Rabbit IgG (ready to use). Counterstained with hematoxylin. Heat mediated antigen retrieval with Tris/EDTA buffer pH9.0 was performed before commencing with IHC staining protocol.
Immunofluorescence

IF shows positive staining in paraffin-embedded human liver . Anti-BSEP antibody was used at 1/1000 dilution (Green) and incubated overnight at 4°C. Goat polyclonal Antibody to Rabbit IgG - H&L (Alexa Fluor® 488) was used as secondary antibody at 1/1000 dilution. Counterstained with DAPI (Blue). Heat mediated antigen retrieval with Tris/EDTA buffer pH9.0 was performed before commencing with IF staining protocol.